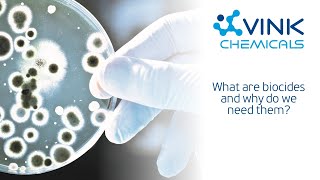

What are biocides and why do we need them? video
Online izle ve mp4 mp3 formatlarinda yukle

Videonun muddeti: 2:18
What are biocides and why do we need them? videosu mp4 ve mp3 yuklemek ucun hazirdir
Diqqet! Siz Mp4 yukle ve ya Mp3 yukle duymesine basdiqdan sonra eger sistem sizi reklam sehifesine atarsa o zaman derhal geri qayidib emeliyyati tekrar edin ve faylin yuklemek ucun hazir olmasini gozleyin
Videodan Mp4 Yukle
Videodan Mp3 Yukle-1
Videodan Mp3 Yukle-2
Oxshar Axtarishlar
 What are biocides and why do we need them?
What are biocides and why do we need them? Endocrine disruptors and biocides: what you need to know
Endocrine disruptors and biocides: what you need to know HSE Chemicals (JAN 21) Biocides
HSE Chemicals (JAN 21) Biocides Easier access to information on biocides
Easier access to information on biocides The impact of biocides tolerance by Lauren Russell
The impact of biocides tolerance by Lauren Russell What is a biocidal product?
What is a biocidal product? Biofilm Minutes - Biocides
Biofilm Minutes - Biocides What are biocidal active substances?
What are biocidal active substances? Your Biocidal Experts
Your Biocidal Experts
Video Mp4 Mp3Azwap.Biz
Azwap.Biz 2021-2023

What are biocides and why do we need them?
What are biocides and why do we need them? Endocrine disruptors and biocides: what you need to know
Endocrine disruptors and biocides: what you need to know HSE Chemicals (JAN 21) Biocides
HSE Chemicals (JAN 21) Biocides Easier access to information on biocides
Easier access to information on biocides The impact of biocides tolerance by Lauren Russell
The impact of biocides tolerance by Lauren Russell What is a biocidal product?
What is a biocidal product? Biofilm Minutes - Biocides
Biofilm Minutes - Biocides What are biocidal active substances?
What are biocidal active substances? Your Biocidal Experts
Your Biocidal Experts